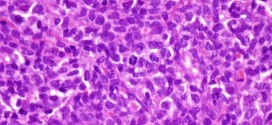

El Sulforafano es una sustancia que se encuentra en los retoños del brócoli, así como en otras verduras, en la familia de la col, como el brócoli, col de Bruselas, col, coliflor, y col rizada. Publicado en: binipatia.com Escrito por: Salvador Gregori y Marry McNeil Etiquetas: crucíferas, brócoli Resumiendo: El Sulforafano. Ése es el nombre de un compuesto que se encuentra en …
Leer MásResultados de: leucemia
GLUCOSINOLATOS
GLUCOSINOLATOS Estudios epidemiológicos sugieren que las verduras del género Brassica ejercen un efecto protector frente al riesgo de sufrir cáncer de pulmón, hígado, etc. Por: Salvador Gregori, binipatia.com Resumiendo: Inhibiendo también el desarrollo de otros tipos de tumores relacionados con el tracto gastrointestinal, etc. Las Crucíferas son una importante fuente dietética de glucosinolatos (compuestos azufrados). Estos compuestos permanecen intactos a …
Leer MásISOTIOCIANATOS
ISOTIOCIANATOS Existen como sus glucosinolatos conjugados en una amplia variedad de vegetales Crucíferos. Cuando se dañan o rompen las células vegetales, la enzima mirosinasa es liberada y cataliza la hidrólisis de los glucosinolatos formando isotiocianatos por un arreglo tipo Lossen. Los isotiocianatos son responsables, en parte del sabor agudo de ciertos vegetales crucíferos. El consumo de cantidades normales de vegetales …
Leer MásBERBERINA
La berberina es una planta alcaloide amarilla y de sabor amargo con un amplio historial de uso médico en la medicina china y ayurvédica. Publicado en: binipatia.com Escrito por: Salvador Gregori y WendyGates Etiquetas: sello de oro, berberina Resumiendo: La berberina está presente en las raíces, rizomas y corteza del tallo de varias plantas, tales como la Hydrastis canadensis (sello de oro), …
Leer MásTrofología/Higienismo
La Trofología/Higienismo: La trofología/higienista es la ciencia que nos enseña a cultivar o restablecer la salud mediante una alimentación de sentido común y adecuada a las necesidades de nuestro cuerpo y Genes. Resumiendo: Es la ciencia que estudia la alimentación natural y científica de cada especie de acuerdo a su constitución física y orgánica (Epigenética y Nutrigenómica). Llevo practicando la …
Leer MásDHA (ácido docosahexaenoico)
El ácido docosahexaenoico (DHA) es un ácido graso esencial poliinsaturado de la serie omega-3. Químicamente es, como todos los ácidos grasos, un ácido carboxílico. DHA es una abreviatura que proviene de su nombre en inglés (docosa-hexaenoic-acid). Se encuentra en el aceite de pescado y en algunas algas. La mayor parte del DHA en peces y otros organismos complejos con acceso …
Leer MásBRÓCOLI o BRÉCOL
Nombre común o vulgar: Brécoles, Brócoli, Bróculi, Brécol. Nombre científico o latino: Brassica oleracea var. Italica Familia: Crucíferas. Publicado en: binipatia.com Sábado, 09 de marzo de 2019 a las 9:10 a.m. Escrito por: Salvador Gregori y Daniel Lynch, WendyGates Etiquetas: brócoli Resumiendo: Origen: su origen parece que está ubicado en los países bañados por el Mediterráneo oriental, en concreto en Oriente Próximo (Península de Anatolia, Líbano, …
Leer MásSELENIO (selenometionina, seleniometionina)
Considero al mineral oligoelemento selenio como uno de la gran sustancia súper y esencial, exactamente igual que la vitamina C. Por: Salvador Gregori Escrivá Resumiendo: El selenio es muy poco asimilable bajo la forma de sal (selenitos, selenatos, etc.), siempre aconsejo que sea de la forma de selenometionina. A principios de los años setenta, el selenio se utilizó en experimentos …
Leer MásREISHI (ganoderma lucidum)
El hongo reishi (ganoderma lucidum) es un hondo de la familia de las ganodermatáceas. Publicado en: binipatia.com Escrito por: Salvador Gregori y Mike Eliaz Etiquetas: reishi Resumiendo: A la ganoderma lucidum también se la conoce con los nombres de lingzhi (lingzhi) en chino, que significa “hongo espiritual”, reishi en japonés, yeongji en coreano, mannentake en inglés. Su nombre más extensamente conocido es «reishi». El hongo reishi se encuentra en 6 colores …
Leer MásGERMANIO (Ge-132)
Historia del Germanio-132: En 1886 el Germanio fue descubierto por el químico alemán Winkler, quien lo bautizó con el nombre de su país natal. Por: Salvador Gregori Escrivá, binipatia.com Resumiendo: En 1967 el Dr. Asai formuló y sintetizó por primera vez un compuesto de Germanio orgánico y lo bautizó como Ge-132. Descubrió su presencia en el lignito de los árboles del …
Leer MásÁCIDO FÓLICO o VITAMINA B-9
El ácido fólico también conocido como (vitamina B9, vitamina L1, folacina, ácido pteroilglutámico, folacín). La palabra “fólico” proviene del latín folium. El ácido fólico es hidrosoluble. Las vitaminas hidrosolubles se disuelven en agua. Las cantidades sobrantes de la vitamina salen del cuerpo a través de la orina. Eso quiere decir que el cuerpo no almacena el ácido fólico y usted …
Leer MásBOSWELLIA (boswellia serrata)
Boswellia serrata, comúnmente conocida como Salai Gugul en Ayurveda. Es un árbol con ramas de unos 4 m. de altura y 1- 1,5 m. de circunferencia. La corteza del árbol es de color verde suave o amarillo y sin foliación. Se encuentra en Rajasthan y Madhya Pradesh en India. Su aroma se considera inferior al compararlos con las especies B. …
Leer MásMIELOFIBROSIS IDIOPATICA
La mielofibrosis idiopática. Es una enfermedad hematológica considerada rara, se caracteriza por una fibrosis de (proliferación del tejido conectivo fibroso) en la medula ósea, y esplenomegalia (desarrollo anormal del bazo) y anemia con una (disminución de los glóbulos rojos de la circulación y de los hematíes) con hematíes en forma de lágrimas. La mielofibrosis idiopática que es la sustitución de …
Leer MásDERMATOSIS PARANEOPLÁSICA
La dermatosis paraneoplásica. Tumor maligno ó manchas malignas en general y especialmente el formado por células epiteliales o pigmentarias. Durante los primeros años de vida de una persona, las células normales se dividen más rápidamente para permitir el crecimiento. El cuerpo está compuesto por billones de células vivas. Las células normales del cuerpo crecen, se dividen formando nuevas células y …
Leer MásLEUCEMIA CUTIS
La leucemia cutis. La Leucemia Cutis (LC) es una enfermedad poco frecuente y se asocia con leucemia mieloide aguda la mayoría de las veces. Puede manifestarse antes o después del diagnóstico de leucemia en sangre o médula ósea. Durante los primeros años de vida de una persona, las células normales se dividen más rápidamente para permitir el crecimiento. El cuerpo …
Leer MásLA LECHE ES DAÑINA PARA SU SALUD
Mas productos lácteos son consumidos en los Estados Unidos que en cualquier otro país del mundo. Solamente el 6% de los americanos dicen no consumir leche en ninguna forma. Por: Salvador Gregori, binipatia.com Resumiendo: Un dólar de cada siete gastado en Estados Unidos es para comprar leche y otros productos lácteos. El promedio de productos lácteos consumido por …
Leer MásLas vitaminas naturales que «suicidan» tumores
Un aspecto de especial preocupación la vitamina o sustancias minerales o de otro tipo que posee anti-tumor selectiva sólo en las células tumorales mediante la inducción de la apoptosis, es decir, para inducir el «suicidio» de estas células sin dañar las células sanas. Medios para la activación de la apoptosis-endonucleasas específicas que el fragmento de ADN, que actúan en puntos …
Leer MásAYUDE A COMBATIR SU CANCER
Dr. MeR AM. Instituto Tecnológico e Instituto de Enfermedades degenerativas graves higienista. Los Ángeles (california) y san Antonio (Texas). Si a usted le han diagnosticado un cáncer recientemente, seguramente le ha preguntado a su médico que tratamientos se pueden realizar para combatirlo. Sin embargo ¿Se ha preguntado qué puede hacer usted para ayudar a combatir este cáncer? Si usted no …
Leer MásRetrovirus endógenos como riesgos potenciales para vacunas.
Artículo Afiliación: Laboratorio de Transducción de Señales, Departamento de Biología Celular, Instituto de Investigaciones Virales de la Universidad de Kyoto, 53 Shogoin-Kawaracho, Sakyo-ku, Kyoto 606-8507, Japón. Resumen: Los retrovirus se clasifican como exógeno o endógeno de acuerdo con su modo de transmisión. En general, los retrovirus endógenos (ERV) no son patógenos en sus hospederos originales, sin embargo, algunos ERV inducir …
Leer Más«La ciudadanía es víctima del marketing del miedo»
Miguel Jara, periodista especializado en investigación de temas de salud y ecología Es el corresponsal en España del British Medical Journal y colaborador habitual de la revista Discovery Salud. La salud que viene, nuevas enfermedades y el marketing del miedo Traficantes de salud y Conspiraciones tóxicas-documenta todos esos aspectos de la industria farmacéutica que para algunos son pura leyenda alarmista …
Leer Más Binipatia e higienismo Medicina natural alternativa, plantas medicinales y remedios caseros naturales
Binipatia e higienismo Medicina natural alternativa, plantas medicinales y remedios caseros naturales